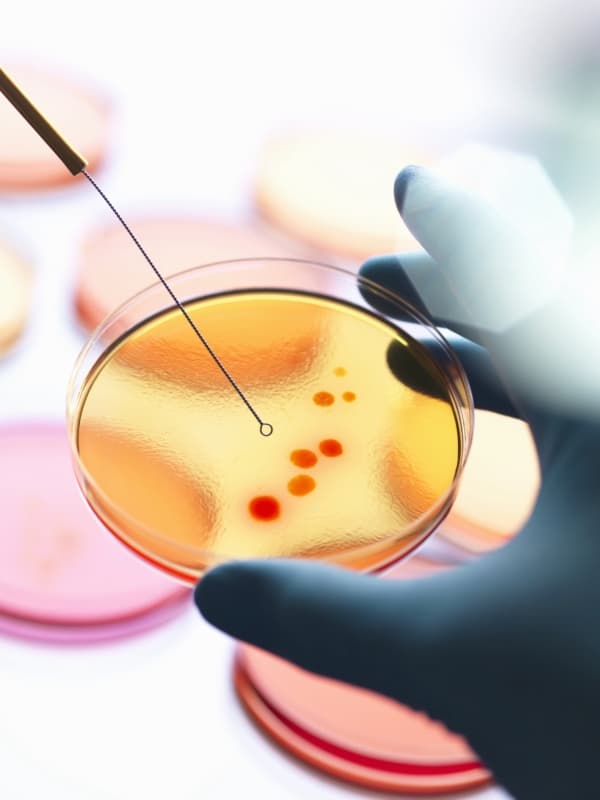
Getty Images 525386715 Agar plates bacteria lab

Our life’s work, is life itself
Environment, Social & Governance
Nxera Pharma is a technology-powered biopharma company, in pursuit of new specialty medicines to improve the lives of patients with unmet needs in Japan and globally.
We have built an agile, new-generation commercial business in Japan to develop and commercialize innovative medicines, including several launched products, to address this high value, large and growing market and those in the broader APAC region. Behind that, and powered by our unique NxWave™ discovery platform, we are advancing an extensive pipeline of over 30 active programs from discovery through to late clinical stage internally and in partnership with leading pharma and biotech companies. This pipeline of potentially first- and best-in-class candidates is focused on addressing major unmet needs in some of the fastest-growing areas of medicine across neurology/neuropsychiatry, metabolic diseases and immunology and inflammation.
Nxera employs approximately 400 talented people at key locations in Tokyo and Osaka (Japan), London and Cambridge (UK), Basel (Switzerland) and Seoul (South Korea) and is listed on the Tokyo Stock Exchange (ticker: 4565).
Our Mission
To accelerate the development of life-changing medicines, by investing in science and technology.

Our Vision
To lead the next era of medicine. From Japan, for Japan, and by extension, to the world.

Our Values
Patients, carers, families, and physicians come first
Innovation and teamwork inspire success
Focus on top priorities where we can make a difference
Speed and agility of decision-making
Operational excellence